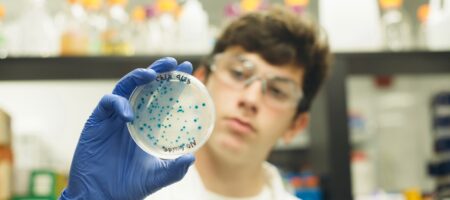
student holding a KnockOut lab plate

Comparing SeeGreen™ and GelGreen® DNA stains for gel electrophoresis
If you’ve ever been stuck on which nucleic acid stain to use in your DNA or RNA electrophoresis experiment, this blog post will help you understand the advantages and disadvantages of using GelGreen® and SeeGreen™, two different fluorescent stains available from miniPCR bio. Fluorescent stains like GelGreen® and SeeGreen™ allow scientists to immediately see their DNA samples as they migrate during gel runs, when used with integrated electrophoresis and visualization systems such as the blueGel™ or GELATO™.
How does GelGreen® nucleic acid stain stack up against SeeGreen™?
Safety
Both SeeGreen and GelGreen are relatively safe alternatives to ethidium bromide. They are non-carcinogenic, can be imaged under safe blue light, and do not require special disposal protocols. In summary, both dyes are classroom friendly and environmentally friendly.
Safety winner: tie
Sensitivity

The photo above says it all: both stains offer high signal-to-noise ratios that make bands pop against a dark background. By the numbers, GelGreen’s sensitivity matches that of ethidium bromide; both stains can label as little as 1 ng of DNA. But SeeGreen beats them both, offering detection of as little as 0.2 ng of DNA.
SeeGreen also beats GelGreen in its sensitivity to light across the spectrum. With dual absorption peaks at 250 and 480 nm, SeeGreen can be imaged under UV or safe blue light with equal sensitivity. GelGreen fluoresces much less brightly under UV compared to blue light.
For its superior detection threshold and versatility under different lighting conditions, this category goes to SeeGreen.
Sensitivity Winner: SeeGreen™
Resolution
As you can see in the image to the right, bands visualized with SeeGreen tend to run sharper and straighter than bands on GelGreen gels. High concentrations of DNA stained with GelGreen tend to “smile”: The interaction between the DNA and the stain causes the ends of the bands to curve upward. When bands are closely stacked across a narrow range of molecular weights, this can interfere with resolution, ultimately requiring more run time to generate clear results. For its crisp, straight bands that enable faster resolution we have to give this category to SeeGreen.
Resolution Winner: SeeGreen™
Migration
SeeGreen offers more uniform migration than GelGreen. The cropped image below shows consecutive lanes containing DNA samples of the same size. After a 40-minute run, the GelGreen gel shows considerable variability in band position, while the SeeGreen-stained bands remain better aligned.
While it’s not apparent in this image, users should note that using SeeGreen for longer gel runs may lead to a loss of staining over time. SeeGreen is itself positively charged, and migrates away from the DNA over time. This results in a loss of staining along the leading edge of a DNA band. Still, for runs up to 40 minutes in length, SeeGreen offers more faithful migration.
Migration Winner: SeeGreen™
Ease of use
When mixed with agarose during gel preparation, both stains enable direct visualization of DNA as the gel runs–no time-consuming staining or de-staining steps required. For added convenience, both are available in All-in-One Tabs™ (SeeGreen Tabs™, GelGreen Tabs™) that combine all the agarose, DNA stain, and buffer you need to cast picture-perfect gels.
Ease of Use Winner: tie
Overall
Both GelGreen and SeeGreen are outstanding choices for DNA and RNA staining in gel electrophoresis, especially when compared to other common fluorescent stains. For those holdouts still visualizing the toxic stain ethidium bromide with damaging UV light, either SeeGreen or GelGreen will deliver comparable results with a better safety profile. And those already using safe blue light and SYBR family dyes will be impressed by the improved sensitivity and photostability these stains offer.
So the good news is, you can’t lose. Still, if we have to pick a winner, we’d have to give SeeGreen the edge. Its fidelity, clarity, and uniformity enable faster resolution and, at the end of the day, shorter runs.
Overall Winner: SeeGreen™
Related resources:
- Blog post: Choosing a DNA stain for classroom use
- Blog post: Choosing the right DNA ladder
- Tutorial: Gel electrophoresis
- Introductory video: Gel electrophoresis